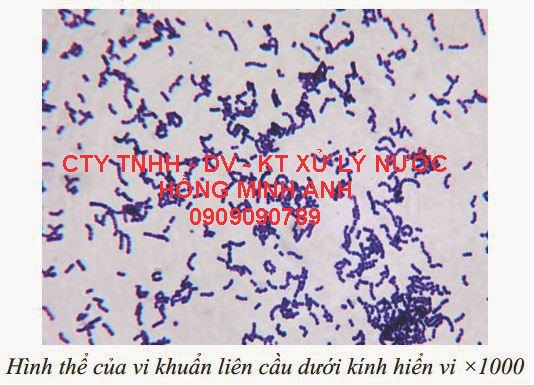
Vi khuẩn Li&ecirc;n ph&acirc;n cầu (LI&Ecirc;N CẦU KHUẨN )

- Điện Năng Lượng Mặt Trời Của Đức
- Công trình tiêu biểu
- Phòng kỹ thuật phân tích mâu nước
- Dây chuyền sản xuất nước tinh khiết
- Hệ thống xử lý nước giếng khoan gia đình công nghiệp
- Máy Lọc nước uống nóng lạnh
- Máy lọc nước nước uống trực tiếp
- Vật tư nguyên liệu lọc nước
- Hệ thống làm mềm nước
- vật liệu lọc nước
- Máy nước nóng năng lượng mặt trời
- Hệ thống lọc nước biển
- Góc riêng tư cây cảnh
- Xử lý nườc thải
Danh mục sản phẩm
Hổ trợ trực tuyến
0909090.789
Hổ trợ Online:
Hỗ trợ khách hàng trực tuyến
Mr: Cường
zalo: 0909090.789
ĐT Bàn: 0251.9999998
Tin tức
 Lọc sạch nước dòng sông linh thiêng của Ấn Độ
Lọc sạch nước dòng sông linh thiêng của Ấn Độ Tìm hiểu nước máy
Tìm hiểu nước máy Lọc nước ngành dược phẩm, bệnh viện
Lọc nước ngành dược phẩm, bệnh viện Kinh nghiệm mua máy ozone gia đình
Kinh nghiệm mua máy ozone gia đình Lo nước ô nhiễm làm bẩn sông Sài Gòn
Lo nước ô nhiễm làm bẩn sông Sài Gòn Kinh hãi nước đóng chai nhiễm khuẩn mủ xanh
Kinh hãi nước đóng chai nhiễm khuẩn mủ xanh Báo động về nguồn nước toàn cầu
Báo động về nguồn nước toàn cầu Hình ảnh đầu tiên về tàu ngầm Kilo HN tại vịnh Cam Ranh
Hình ảnh đầu tiên về tàu ngầm Kilo HN tại vịnh Cam Ranh Tìm hiểu về máy lọc nước
Tìm hiểu về máy lọc nước LỊCH SỬ CÔNG NGHỆ LỌC NƯỚC THẨM THẤU NGƯỢC
LỊCH SỬ CÔNG NGHỆ LỌC NƯỚC THẨM THẤU NGƯỢC CÂU HỎI THƯỜNG GẶP KHI MUA VÀ SỬ DỤNG MÁY LỌC NƯỚC R.O
CÂU HỎI THƯỜNG GẶP KHI MUA VÀ SỬ DỤNG MÁY LỌC NƯỚC R.O ĐÈN CỰC TÍM (UV) TRONG XỬ LÝ NƯỚC CÓ TÁC DỤNG GÌ?
ĐÈN CỰC TÍM (UV) TRONG XỬ LÝ NƯỚC CÓ TÁC DỤNG GÌ? TÌM HIỂU VỀ VIỆC ỨNG DỤNG CÔNG NGHỆ NANO
TÌM HIỂU VỀ VIỆC ỨNG DỤNG CÔNG NGHỆ NANO Đảo dừa Bến Tre khát nước ngọt
Đảo dừa Bến Tre khát nước ngọt  Nước đóng bình giá rẻ: Ung thư ở đây chứ ở đâu!
Nước đóng bình giá rẻ: Ung thư ở đây chứ ở đâu!
Thống kê truy cập
Online: 13
Lượt truy cập: 422016
Lượt truy cập: 422016